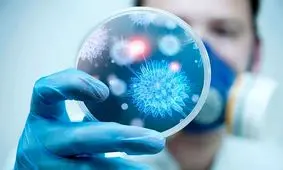
محیط گرم مستعد شیوع بیماری های عفونی است

بیماری های عفونی
-

این گروه بهطور ویژه نسبت به آنفلوانزا آسیبپذیرند
متخصص بیماریهای عفونی گفت: کودکان زیر پنج سال به طور ویژه نسبت به آنفلوانزا آسیبپذیر هستند.
-
محیط گرم مستعد شیوع بیماری های عفونی است
رئیس مرکز تحقیقات بیماری های عفونی دانشگاه علوم پزشکی شهید بهشتی گفت: تهویه و مصرف مایعات مناسب سبب رفع بیماری های…
-

اسهال و استفراغ همراه با تب را جدی بگیرید
در مسافرت خطر بیماریهای عفونی زیاد میشود. یک متخصص بیماریهای عفونی تاکید میکند، اگر در سفر با اسهال و استفراغ…
-

پیش بینی یک مقام بهداشتی انگلیس در مورد آبله میمونی در این کشور
یکی از مدلسازان پیشرو در حوزه بیماریهای عفونی در انگلیس اظهار کرده است که وضعیت شیوع بیماری آبله میمونی در این کشور…
-

تب گوجه فرنگی چند روزه درمان می شود؟
یک متخصص بیماریهای عفونی درخصوص بیماری تب گوجه فرنگی که گفته میشود اخیرا در هند بروز و شیوع یافته، توضیحاتی ارائه…
-

تفاوت علائم بیماری کرونا با بیماری سرخک
یک فوق تخصص بیماری های عفونی به سه سوال در رابطه با بیماری سرخک پاسخ داد.
-

پایان عصر بیماریهای ژنتیکی و آغاز عصر بیماریهای ویروسی/ ادعایی درست یا غلط؟!
برخی بر این باورند که عصر بیماریهای ژنتیکی در دنیا پایان یافته و بشر وارد عصر بیماریهای ویروسی شده است.
-

دیابت و افزایش خطر ابتلا به عفونتهای تنفسی ویروسی
افراد مبتلا به دیابت نه تنها احتمال بیشتری دارد به عفونت های تنفسی مبتلا شوند، بلکه شدت عفونت های تنفسی در آنها بیشتر ا…
-

خاطر جمعی رئیس انجمن متخصصان بیماریهای عفونی درباره ملخها
رئیس انجمن صنفی متخصصان بیماری های عفونی و میکروبیولوژیکی ایران با اشاره به هجوم ملخ ها به مناطق سیل زده گفت: ملخ ها…
